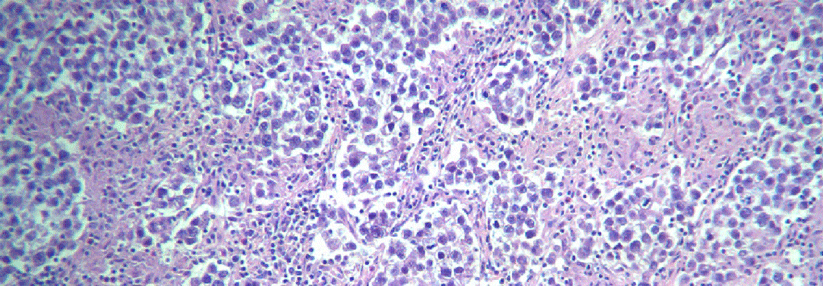

Seminom IIA/B Reif für die Routine?
 Auf dem EAU wurden neue Therapiestandards für Patienten mit seminomatösen Keimzelltumoren diskutiert.
© M+Isolation+Photo – stock.adobe.com
Auf dem EAU wurden neue Therapiestandards für Patienten mit seminomatösen Keimzelltumoren diskutiert.
© M+Isolation+Photo – stock.adobe.com
Auf der diesjährigen Jahrestagung der European Association of Urology (EAU) wurden im Rahmen einer multidisziplinären Paneldiskussion die Therapiestandards und mögliche neue Therapieoptionen für Patienten mit seminomatösem Keimzelltumor und kleinvolumiger retroperitonealer Metastasierung diskutiert.
Die klinische Stadieneinteilung und stadienadaptierte Therapiemaßnahmen richten sich nach der Größe der retroperitonealen Lymphknotenmetastasen (klinisches Stadium IIA, Lymphknoten bis 2 cm im maximalen Durchmesser; klinisches Stadium IIB, Lymphknoten mit > 2 x, bis ≤ 5cm). Bisher war der Therapiestandard im Stadium IIA und IIB eine Kombinationschemotherapie mit 3 Zyklen Cisplatin, Etoposid und…
Bitte geben Sie Ihren Benutzernamen und Ihr Passwort ein, um sich an der Website anzumelden.

